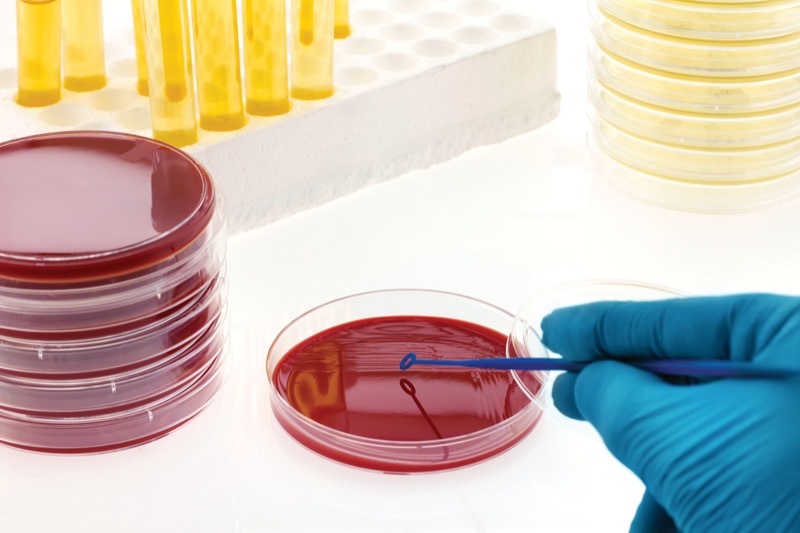

Urinary tract infections (UTIs) are one of the common bacterial diseases encountered in clinical medicine, impacting patients across diverse demographic groups. Global estimates of burden include more than 400 million cases annually, as a majority of women—who are disproportionately affected, especially when younger—will experience at least 1 UTI during their lifetime.1 Recent years have witnessed significant advances in our understanding of the epidemiology and pathogenesis of UTIs, especially as they pertain to the complex host–microbe interactions within the urinary tract.2 During this same period, advances in molecular technology have made nucleic acid amplification tests (NAATs) the new diagnostic norm for other common infection types (eg, respiratory, gastrointestinal).3 Nevertheless, routine implementation of such techniques for characterizing UTIs has lagged.
Thus, the field lies at an exciting and challenging juncture: There are clear opportunities for diagnostic advances but also unresolved questions about how new UTI assays should be employed (and interpreted) to maximize their added value. This includes their application to different clinical care scenarios, from routine outpatient management to specialized testing for high-risk populations. In this context, this review article summarizes the laboratory methods that UTI diagnostics traditionally have entailed, the new directions in which they are moving, and the myriad factors guiding this progression. Overall, I seek to provide the reader with a better understanding of the combined strengths and limitations of different techniques, both established and developing.
How Are UTIs Traditionally Diagnosed?
At present, routine diagnostic practices for UTIs remain what they have been for many years. An understanding of this foundation is key to appreciating more recent diagnostic advances. For starters, it is important to note that not all patients with suspected UTIs necessarily require explicit in-lab testing.4 UTIs are broadly characterized as either uncomplicated or complicated, based on clinical criteria of the affected individual,5,6 although these definitions recently have undergone revisions by the Infectious Diseases Society of America (IDSA).7 Traditionally, uncomplicated UTIs (uUTIs) involve nonpregnant, immunocompetent adult cisgender women without any structural/functional urologic abnormalities; they represent mainstay conditions encountered in primary care medicine. By contrast, complicated UTIs (cUTIs) were defined broadly as infections in patients who do not fall into the uncomplicated category—this includes cisgender men, children, and people with any number of predisposing conditions (eg, catheterization, urolithiasis, neurogenic bladder).
In July 2025, however, new IDSA treatment guidelines for cUTIs were promulgated that substantially reformulated the distinction between uUTI and cUTI.7 Under this updated paradigm, uUTIs are defined as afebrile infections that remain anatomically limited to the bladder, regardless of patient sex and (most) predisposing risk factors. By contrast, cUTIs include patients with fever, infection of the kidneys (pyelonephritis) or prostate, or concomitant bacteremia. Catheter-associated infections are also inherently considered complicated.
Temporally, UTIs are defined as recurrent if multiple infections (2 in 6 months or 3+ in 1 year) are observed for a person with intervening periods of clinical resolution.8
For nonrecurrent cases of suspected simple cystitis, diagnoses frequently are made on clinical grounds, including empiric selection of antibiotics. Basic urinalysis testing—including point-of-care (POC) dipsticks and newer analyzers—frequently inform routine outpatient evaluations. Urinalysis comprises a set of semiquantitative biomarkers indicative of possible infection.9 For instance, nitrates are a metabolic byproduct of many (but not all) uropathogenic bacteria, while leukocyte esterase and blood reflect the host’s inflammatory response. While the precise sensitivity/specificity may vary among modalities, negative urinalysis findings significantly lower the overall suspicion for infection.10
However, beyond POC testing, urine specimens suspected of uUTI (as currently or previously defined) may not always be forwarded to a central laboratory for bacterial culture and an organism-specific diagnosis. In fact, this practice can be justified largely by the underlying microbiological epidemiology and pathogenesis of UTIs.
Most infections in patients without significant predisposing factors (corresponding largely to uUTI, as previously defined) were caused by strains of Escherichia coli (termed uropathogenic E. coli or UPEC) that ascend into the bladder from a commensal gut niche.11,12 Several other bacterial species, likewise acquired endogenously, are known to elicit infections in individuals without significant premorbidities. These organisms include Klebsiella pneumoniae, Staphylococcus saprophyticus (classically in young women), and occasionally others. Antimicrobial resistance can occur in these bacteria (including intrinsic fosfomycin resistance in S. saprophyticus), although first-line treatment guidelines entail antibiotics (ie, nitrofurantoin, trimethoprim-sulfamethoxazole, fosfomycin, pivmecillinam [Pivya, Utility Therapeutics]) where, probabilistically speaking, the likelihood of appropriate coverage is very high, even if the offending species remains undefined. In fact, when treatment failure does occur, the cause is often not attributable to frank bug–drug mismatch.4-6
On the other hand, in the context of structural/functional urologic risk factors, the epidemiological landscape of cUTIs is far more complex. This is a natural consequence of the fact that these represent opportunistic infections. The very same risk factors that (previously, at least) classified a UTI as complicated also provide a microbe with the opportunity to infect the bladder, even if it holds lower inherent pathogenicity for healthy individuals. Not surprisingly, the organisms that elicit such infections (including as polymicrobial UTIs) are far more diverse taxonomically.13 They include additional species/genera within Enterobacterales (Proteus, Serratia, Enterobacter, and others), Pseudomonas aeruginosa and other nonfermentative gram-negative rods, Enterococcus spp, Staphylococcus aureus, pyogenic streptococci, and Candida spp (yeasts). As cited by individual case reports/series, the taxonomic diversity of UTI pathogens is vast, including species that are more commonly resistant to first-line oral antibiotics. In this context, the need for diagnostic culture arises.
Established for decades, these procedures involve the semiquantitative culture of borate-treated urine (a bacteriostatic agent that halts their proliferation ex vivo). A small volume (1-10 mcL) of specimen is streaked onto several plate-based media, which often include a general-purpose agar (eg, blood agar), a gram-negative–selective agar (MacConkey agar), and a gram-positive–selective agar (CNA agar). Additional selective/differential media also may be employed, including chromogenic agars that provide a preliminary identification of resultant growth through conserved color changes.
After 16 to 24 hours of incubation under aerobic conditions (key parameters addressed again later), plates are visualized for the presence of bacteria, and the number of colony-forming units per milliliter of urine (CFU/mL) is approximated for each distinct colony type.14 This process of inspection traditionally was performed manually, although clinical laboratory automation and digital imaging increasingly now are incorporated, often with noted improvements to turnaround/workflow for urine cultures.15 The CFU/mL value is used to infer the relevance of a given isolate as a potential uropathogen (with no growth treated as the physiologic reference result). For voided (midstream) urine specimens, 105 CFU/mL or higher is interpreted as the clearest threshold for clinical significance, while 104 CFU/mL or higher is typically employed for specimens collected by in-and-out catheterization.14
Following isolation, colonies are identified—either presumptively or definitively if matrix-assisted laser desorption/ionization time-of-flight (MALDI-TOF) mass spectrometry is available—and empiric antimicrobial susceptibility testing (AST) is performed. The latter may be conducted by either minimum-inhibitory concentration or zone-of-inhibition methods. The result of this diagnostic pipeline is a semiquantitative bacterial species result, together with that strain’s antibiogram.
Increasingly, in-lab urine cultures may be combined with urinalysis using an algorithm. Here, the negative predictive value of urinalysis is leveraged to identify specimens whose parameters are inconsistent with infection, which can then be excluded from culture.16
Strengths and Limitations of Traditional Culture
These procedures are considered the diagnostic gold standard for UTIs, and the fact that they have persisted for so long implies certain strengths. Most importantly, culture generates an empiric taxonomic identification and phenotypic susceptibility profile. In the process, it allows clinicians to infer the diagnostic adequacy of the urine specimen itself. Contamination with periurethral flora is a potential concern for noncatheterized specimens, often manifesting as 3 or more distinct colony types on agar plates.14 This level of polymicrobial growth typically is interpreted as a contaminated specimen, and laboratories often perform no further workup of any such colonies. Moreover, the relatively inexpensive nature of culture-based microbiology also can be viewed as an advantage from the perspective of healthcare economics.
However, just because a technique holds the mantle of gold standard does not imply it is without any weaknesses, including potentially significant ones. In many ways, urine cultures epitomize this inconvenient truth. Of note, the timing of urine cultures can limit their clinical actionability. From the time that a specimen is collected to when a bacterial species is reported, 1 to 2 days will have passed, and at least another day is required before AST data are available. Antibiotic choices remain empiric during this period, creating a long window for inadequate therapy in the event of a bug–drug mismatch.
Time considerations aside, the interpretation of culture-based data can present challenges on a patient-to-patient level. The aforementioned threshold of 105 CFU/mL originated from historical data on E. coli,17,18 although it is now applied broadly across bacteria (often with far less direct evidence).19 It is well recognized that symptomatic infections can occur in some people at lower bacterial burdens, even potentially below the limit of detection of a 1-mcL inoculum (eg, 1,000 CFU/mL).20 Conversely, in the phenomenon of asymptomatic bacteriuria (ASB), an ostensibly uropathogenic species is observed in a patient’s urine at high concentrations but without any associated symptoms (instead behaving as a commensal). With several exceptions (eg, pregnant women, renal transplant recipients), ASB is not viewed as condition that requires antibiotic therapy, such that obtaining cultures from asymptomatic people is not indicated in the first place.21 Nevertheless, the phenomenon of ASB underscores the challenge that associating a bacteriologic result to a clinical picture is not a one-size-fits-all correlation.
Even more challenging are uropathogens that may evade detection by the culture-based methods employed by clinical laboratories.22 Further expanding upon UTI diversity, some bacterial species occasionally elicit UTIs that do not robustly proliferate under the conditions described above. Instead, they may require alternate growth media, longer incubation times, and/or different ambient atmospheres (oxygen-limited and/or carbon dioxide [CO2]-enhanced) to achieve visible colonial growth. These species include Gardnerella vaginalis,23 Actinotignum schaalii, Alloscardovia omnicolens, Aerococcus urinae,24 Corynebacterium urealyticum (and other lipophilic diphtheroid),25 Haemophilus influenzae,26 and others. The term emerging uropathogen can be applied to such organisms, albeit with some imprecision. (Are the species themselves emerging as pathogens or are we just recognizing what has been there all along?) Either way, culture-based identification of these bacteria can require protocols that go beyond clinical standard of practice for urine.
Paradigm Shifts in Urogenital Ecology
The challenges of fastidious uropathogen species go hand in hand with a recent explosion of knowledge on the human urogenital microbiome. Traditionally, urine was considered to be a physiologically sterile body fluid, for which commensal microbial populations are absent in healthy individuals. In fact, this belief stemmed from the traditional methods by which urine cultures are performed diagnostically. As mentioned above, no growth is treated as the reference result for such testing, as specimens from most healthy individuals generate no observed bacteria (ASB or periurethral contamination not withstanding). Again, these protocols are methodologically limited.
Over the past decade, investigators have recognized that the same modifications to culture techniques (eg, longer incubation, alternate media/atmospheres) can yield bacterial populations that fail to proliferate otherwise, including in specimens from healthy subjects.27,28 In this context, urine is viewed more appropriately as a colonized body fluid, with variable-level ASB as the physiologic norm (albeit often with culture-fastidious organisms).
This phenomenon has prompted a flurry of interest in the urobiome, including how its population structure affects (or is affected by) other urological conditions. Various articles have reviewed these burgeoning avenues of discovery.29-31 The urobiome certainly holds diagnostic implications, including for the evaluation of diseases that are viewed classically in nonmicrobial terms (eg, incontinence, overactive bladder, interstitial cystitis). For instance, could particular urobiome signatures hold diagnostic or prognostic associations, especially if these populations could be modified in a targeted manner?
These are admittedly early stage questions, as microbiome diagnostics (in general) face various outstanding issues, both analytic and interpretive.32 Nevertheless, recognition of the urobiome is an important advance in our broader understanding of the host–microbe landscape.
In terms of evaluating UTIs, the existence of the urobiome does raise additional challenges. This is especially true for some of the aforementioned uropathogens with more fastidious growth characteristics. Although they have been associated with UTI symptomatology in certain people, some of these species also have been encountered during urobiome profiling of healthy subjects. For instance, while A. schaalii (a gram-positive microaerophile) has been cited as an underrecognized cause of UTIs in the older adults,33 it also now appears to be a common bladder commensal of infants.34
Historically, infectious disease testing has followed a binary model in which the detection of an organism implies pathology and its absence implies health. For some urinary bacteria, however, a pathobiome view may be more realistic, in which the relationship between the presence of a microbe and the presence of disease is modified by other host/environmental factors.35
While fascinating scientifically, this paradigm reframes the interpretation of diagnostic data on a patient-by-patient basis. Simplistically, such considerations already occur for species like E. coli when differentiating UTIs from ASB (classically defined). For a patient with dysuria, E. coli at 105 CFU/mL is interpreted as a pathogen that requires antibiotics; conversely, the same organism in an asymptomatic nonpregnant woman is viewed as a colonizer that requires no treatment. Are similar criteria—including quantitative thresholds and relevant host factors—required for each of the numerous other emerging uropathogens? If so, the knowledge gap that separates us from comprehensive evidence-based practice could be substantial.
In the meantime, research studies have attempted to apply enhanced/expanded quantitative urine cultures (EQUC) to people with suspected UTIs to cast a broader microbiologic net.36,37 Not surprisingly, this approach generally captures greater organismal diversity. In one randomized clinical trial, bacteriologic culture results (standard vs enhanced) were reported to managing providers, who interpreted and acted upon them according to their own clinical judgment. Trends toward higher culture positivity and symptom resolution (for non–E. coli infections) were observed in the EQUC arm, although powering considerations limited these conclusions.38 Of note, the EQUC protocol here entailed a 100 mcL inoculum of urine, with 1 additional day of incubation (48 hours total) under CO2-supplemented conditions; it did not employ some of the more dramatic enhancements used in culturomic urobiome studies (eg, 5+ days of incubation with microaerobic/anaerobic incubation).
Naturally, enhanced culture (and the workup of the additional isolates) can entail significantly greater laboratory efforts. Workflows that are possible for urobiome research may be less practical for routine patient care—along with the potential isolation of bacteria of ambiguous significance—and EQUC currently remain outside most clinical lab procedures.
Technological Strategies Beyond Culture-Based Microbiology
A broader trend in diagnostic microbiology over the past 20 years has been the advent of NAATs—most notably the polymerase chain reaction (PCR)—to identify bacterial and viral pathogens, sometimes replacing culture-based techniques in routine care (and as the recognized gold standard).3 The added value of molecular testing often lies in its turnaround time, especially when traditional culture is slow or cumbersome for a given target. These technologies include the advent of syndromic molecular testing, in which highly multiplexed PCR reactions are applied to infection scenarios for which numerous alternate pathogens may be responsible.39 They often incorporate automated microfluids to facilitate high-order multiplexing and specimen-to-result workflow capabilities. In the United States, several commercial syndromic platforms have received FDA approval/clearance; thus, these assays are classified as in vitro diagnostic (IVD) devices for broad implementation across credentialed clinical laboratories. These include panels for respiratory,40 gastrointestinal,41 bloodstream,42 central nervous system,43 and bone and joint infections.44 Some of these assays have been a focus of previous reviews in this publication.45
To date, no syndromic molecular assays have been launched in the United States for UTIs, although several remain in commercial development with research-use only (RUO) status. These include new urine panels for at least one existing multiplex system (QIAStat-Dx, Qiagen) as well as several entirely different platforms from other manufacturers. Most entail PCR-based amplification, including real-time PCR and its ability for target quantification, which may be particularly relevant for UTI diagnostics vis-à-vis semiquantitative culture benchmarks. These products were the focus of a separate recent article.46 If/when any of these assays progress through FDA trials, it will be interesting to learn how many (and which) bacterial species are ultimately included in the IVD-approved protocols.
Among existing syndromic panels (eg, respiratory, gastrointestinal), some target variability does exist between different manufacturers. This situation could be even more pronounced for UTIs, given the massive diversity of potential causative species that cross a spectrum from common to rare (and even ambiguous). In broad strokes, molecular detection could circumvent challenges that arise from the variable culture requirements among these different uropathogens.
In addition to syndromic panels, other UTI diagnostics are progressing through the research and development pipeline, presumably toward IVD status. Building on traditional urinalysis, several of these technologies could serve as an initial means of evaluating a urine specimen prior to any downstream testing. For instance, several biochemical assays would evaluate for the presence of additional host- or pathogen-associated biomarkers to inform the likelihood of bacteriuria. These include POC-intended tests for the presence of bacterial catalase, as well as host-derived matrix metalloproteinase-8 and neutrophil elastase.47 Alternatively, some technologies directly assess the presence of moderate/high-level bacteriuria through optical techniques, either macroscopic48 or microscopic.49 This includes 1 assay that has already achieved IVD status in the United States: the BacterioScan 216Dx UTI System, which employs laser light scattering to assess for 50,000 CFU/mL or more organisms.50 Finally, by combining miniaturized rapid culture with biosensing, it may be possible to split the difference in the time required for urinalysis versus traditional culture, facilitating initial positive/negative culture results at the POC.
Beyond identifying and/or speciating urinary bacteria, additional techniques and technologies focus on that other key piece of the equation solved by traditional culture: the antimicrobial susceptibility profiles of the uropathogen. As discussed above, the traditional stepwise process for microbial characterization entails: 1) growth, 2) isolation, 3) identification, and 4) phenotypic susceptibility testing. Investigators have considered—and for quite some time—whether this last analysis might be combined with the preceding steps.
The fact that urine is a natural liquid matrix (with suspended bacteria) could facilitate direct-from-specimen AST in a relatively straightforward manner. Here, urine would be inoculated directly into/onto an antibiotic-supplemented broth/plate for subsequent incubation and observation of growth. Even applying traditional visual standards of growth inhibition, this process could generate next-day results, concomitant to (or before) taxonomic identification.51,52
Nevertheless, important caveats apply that have limited broad implementation of such protocols across clinical labs. Aside from the nonstandardized nature of the bacterial inoculum, the AST data must be correlated ultimately to the taxonomic results to ensure biological plausibility. Polymicrobial urine specimens (including low-level colonization or contamination) can generate uninterpretable or grossly misleading data for population-based AST, especially if providers do not appreciate the intrinsic resistance profiles of certain organisms. No IVD devices are available in the United States that rely on direct urine inoculation, although one European IVD platform employs urine-inoculated broth, with antibiotic inhibition assessed rapidly via light scattering (Alfred 60AST, Alifax).48
Other direct-from-urine technologies for AST attempt to surmount these limitations (and further expedite turnaround) by evaluating antibiotic inhibition on a single-cell level through microscopic imaging or biophysical properties. One such product is likewise approved in Europe (including for potential POC use) but not yet in the United States. The Sysmex Astrego employs nanofluidic-coupled single-cell imaging to generate AST results from urine in about 30 minutes.53 Several additional RUO/in-development platforms for rapid urine AST are further reviewed in the literature.46
The Laboratory-Developed Test: Options and Challenges for UTIs
The preceding section pertains to discrete commercial products that, presumably, would be deployed across individual clinical laboratories (or clinics) following FDA approval and IVD status. At the same time, an alternate pathway exists by which diagnostic assays can be developed/launched for clinical care, including significant relevance for UTI testing: the laboratory-developed test (LDT). In the United States, the classes of performance characteristics required of any diagnostic assay (before it can be implemented for patient care) are defined legally by the Clinical Laboratory Improvement Amendments (CLIA) of 1988.54 In effect, IVD status implies FDA endorsement that CLIA performance characteristics have been met for that test.
At the same time, individual CLIA-credentialed laboratories traditionally have been permitted to launch their own LDTs for patient use, following local validation of these parameters. (Of note, LDTs performed on specimens from patients in New York also must be approved by the New York state Department of Health, through its Clinical Laboratory Evaluation Program [CLEP].)
Often, LDT development is driven by scenarios where there is a lack of available commercial options for a given diagnostic need. They are often used by academic health centers, although an LDT validated by a given institution can only be employed by/at that site (the same procedure performed by a different CLIA laboratory would have to be fully revalidated there).
The position of the FDA—and its parent institution, the Department of Health and Human Services—toward LDTs has varied considerably, with changes over time and with different presidential administrations. It has ranged from a posture of enforcement discretion to a desire for explicit regulation. In 2024, a final FDA ruling was promulgated indicating a move toward direct federal oversight of many types of LDTs beginning in 2025.55 However, more recently, federal courts ruled that such oversight lies outside the FDA’s purview (Association for Molecular Pathology v FDA, 2025),56 a decision that is not being further appealed. Barring any future federal legislation, this returns options for LDT validation back to their longstanding status quo.
In addition to individual healthcare systems and institutions, LDTs increasingly have been leveraged by private reference laboratories as a means of commercializing a particular technique or diagnostic product. Molecular diagnostics are among the most common examples of this phenomenon, including in the realm of infectious disease testing. In recent years, several reference laboratories have launched extensive PCR panels for detecting bacteria (and yeast) in urine, in some cases for more than 20 individual targets.57 These groups include ACCU Reference Medical Lab (New Jersey), Advanta Genetics (Texas), Clarity Lab Solutions (Florida), Core BioLabs (Ohio), Medical Diagnostics Laboratories (New Jersey), MicroGenDX (Florida), and Pathnostics (California). Most of these sites likewise incorporate nontraditional antimicrobial susceptibility testing for uropathogens, including direct-from-urine phenotypic testing and/or PCR detection of antimicrobial resistance genes. In certain cases, the presence of such genes can predict phenotypic resistance in the encoding organisms. (Of note, the molecular prediction of resistance is not the same thing as prediction of susceptibility, particularly in gram-negative species, which can depend on the interplay of multiple genes/alleles that are not easily parsed by single-target PCR).
In addition to multiplex PCR, several current LDTs also employ next-generation sequencing (NGS) to detect urinary bacteria in a metagenomic (ie, target agnostic) fashion. These include Advanta Genetics, Biotia, and MicroGenDx.46,58 Across different infection syndromes (eg, bloodstream, respiratory, central nervous system), diagnostic metagenomics represent an emerging strategy to detect pathogens most broadly. Metagenomics does not represent a specific technique; rather, it is a class of analytic methods that replace organism-specific amplification reactions with the ultra-deep capabilities of post–Sanger sequencing technology (ie, Illumina, Nanopore), including in combination with probe-capture techniques to enhance targets. UTIs represent an additional use case for NGS diagnostics, as reviewed in several recent meta-analyses.59,60 Although, like PCR, metagenomic analyses cannot in themselves differentiate uropathogens from urocolonizers. Research studies to date, mostly outside the context of CLIA testing, have likewise been characterized by significant methodologic heterogeneity. Diagnostic motivations aside, NGS-based metagenomic techniques have become an important tool for the emerging field of urobiome research.
Overall, these reference-lab LDTs make it possible for a clinician to obtain a culture-independent molecular profile of a patient’s urine under the auspices of CLIA testing. At the same time, several factors should be considered when pursuing such diagnostics. First and foremost, it is the responsibility of the ordering provider to interpret the resultant data in the context of the patient’s individual clinical picture. In a desire for broad coverage, most of these commercial LDTs include bacterial targets that have been variably described (on a case-by-case basis) as both emerging uropathogens and urinary commensals. Thus, a physician may be faced with decisions on whether/how to act on the detection of certain targets for which there are no clear guidelines. Moreover, across these various LDTs, there is a dearth of extant data comparing how their results correlate with one another. In some cases, the underlying validation data may not be fully published nor available in the peer-reviewed literature. On a practical level, the billing and reimbursement dynamics of reference testing can vary depending on the particular laboratory, institution of the ordering provider, patient, and payor. Generally speaking, it is advisable for a clinician to explore these factors for a given patient/assay in advance to avoid any unforeseen complications. Providers in New York State also must verify that a particular LDT has received in-state CLEP approval. Aside from a patient’s location, CLEP status also is viewed commonly as an indication that an LDT has been independently reviewed for some level of analytic rigor.
Broader Forces Affecting Development and Implementation
As preceding sections indicate, various technologies could alter the traditional diagnostic approach to UTIs in the years to come, from the POC to specialized reference laboratories. Nevertheless, a key truism applies to these potential changes, one that goes beyond UTI testing (or diagnostics in general): The existence of a given technology does not guarantee it will translate into broader, real-world impact. In fact, some of the most pressing questions facing new UTI diagnostics do not involve their analytic capabilities but their proper use. Returning to the article’s initial message, the clinical circumstances of UTIs are diverse—from routine uncomplicated infections to extremely at-risk patients—and not all cases require culture-based testing. In theory, one could envision more widespread use of novel testing methodologies (perhaps even for uncomplicated infections) if it could further reduce the risk for misdiagnosis, unnecessary treatment, or bug–drug mismatches. But implementation always holds cost–benefit considerations, implying the cost of a new assay would have to be low, especially if it is replacing a standard of no testing. Squaring this need with the commercial nature of many new assays represents a challenge; as a result, complicated infections may represent the most fitting target for many new technologies. In fact, cUTIs (as previously defined) are the explicit focus for several of the molecular products currently in development (or already launched as LDTs).
In many ways, UTI diagnostics could benefit from lessons that were learned (some might say the hard way) from other syndromic molecular assays over the past 10 to 15 years. For instance, when respiratory pathogen panels were first launched, some envisioned a future in which even routine respiratory infections (in outpatient settings) could receive an explicit microbiologic diagnosis. The desire for more information is laudable, but one also must consider the clinical actionability of the various targets. While some respiratory viruses carry specific management strategies (eg, influenza, SARS-CoV-2, respiratory syncytial virus), others entail only supportive care, especially for mild infections of the upper respiratory tract (ie, a cold). At the same time, the simultaneous molecular interrogation of numerous targets entails larger reimbursement rates, as dictated in the United States by current procedural terminology codes. Perhaps not surprisingly, restrictions soon arose (by both federal and private payors) on what clinical scenarios qualify for comprehensive syndromic analyses.
The resultant status quo is one where many routine outpatient care scenarios do not qualify for syndromic panel reimbursement, limiting their application to more severe infections and specialized patient circumstances. Even for testing of admitted patients, difficult questions can arise regarding the optimal use of syndromic testing (respiratory or otherwise). This stems largely from the fact that inpatient laboratory testing in the United States also is not directly reimbursed, motivating detailed cost–benefit considerations across healthcare institutions. Conversely, from the perspective of a diagnostic manufacturer, a test with broader projected implementation carries greater motivation for development—and ultimate potential for profit.
Similar dynamics would apply to any future UTI diagnostics, whether involving PCR panels, NGS, or novel AST modalities. In fact, these questions highlight a more general issue that has emerged across laboratory medicine in light of new technologies: a need for implementation research that demonstrates the impact of new diagnostics on patient care and healthcare economics. Traditionally, laboratory assays have been defined in terms of their analytical performance characteristics. But given their increased complexity, a strong desire arises to justify the implementation (and cost) of these assays through attributable outcomes. For UTI testing, relevant questions would address the impact of the testing techniques and the targeted patient populations themselves (ie, the specific risk factors that qualify their infections as complicated).
To these ends, a limited body of (manufacturer-sponsored) outcomes data have been published for several urinary LDTs.61 However, overall, the field of diagnostic implementation research remains in its infancy and formidable challenges remain, including challenges resulting from the funding models that might support such studies at the scale they are needed.
Conclusion
As the preceding discussion highlights, the current landscape of UTI diagnostics is one that can elicit a combination of both enthusiasm and uncertainty. It is widely acknowledged that the historic gold standard of clinical culture is beset by key flaws, both analytically and in its ability to provide results in a clinically meaningful time. In parallel, advances in molecular biology and biomedical engineering have generated technologies that, at first glance, would seem to represent the natural heir apparent to traditional culture. Nevertheless, the dynamics and timing of such a succession remain far from certain.
In many ways, UTI testing epitomizes some of the larger paradigm shifts that are occurring in laboratory medicine in light of high-throughput nucleic acid techniques. Scenarios arise where information comes easier than knowledge; that is, an ability to generate a large body of data is more straightforward than its clinical interpretation. Likewise, laboratory technologies can become available before the logistical/financial models that govern their implementation. Needless to say, any innovation without practicable use cases cannot reach its full potential. To these ends, recent developments would suggest the field is moving in a positive direction. But the future state of what UTI standard-of-care testing becomes will continue to hinge on factors beyond just the tests themselves.
References
- Zeng Z, et al. World J Urol. 2022;40(3):755-763.
- Klein RD, et al. Nat Rev Microbiol. 2020;18(4):211-226.
- Schmitz JE, et al. J Clin Microbiol. 2022;60(10):e0244621.
- Kurotschka PK, et al. Am Fam Physician. 2024;109(2):167-174.
- Gupta K, et al. Clin Infect Dis. 2011;52(5):e103-e120.
- Kranz J, et al. Eur Urol. 2024;86(1):27-41.
- Trautner BW, et al. IDSA Practice Guidelines. July 17, 2025. Accessed September 11, 2025. idsociety.org/practice-guideline/complicated-urinary-tract-infections/
- Anger J, et al. J Urol. 2019;202(2):282-289.
- Hitzeman N, et al. 2022;106(1):27-35B.
- Werneburg GT, et al. Urology. 2023;175:101-106.
- Foxman B. Nat Rev Urol. 2010;7(12):653-660.
- Mancuso G, et al. Pathogens. 2023;12(4):623.
- Wagenlehner FME, et al. Nat Rev Urol. 2020;17(10):586-600.
- McCarter YS, et al. Cumitech 2C, Laboratory Diagnosis of Urinary Tract Infections. ASM Press; 2009.
- Kritikos A, et al. Diagnostics (Basel). 2024;14(13):1392.
- Yarbrough MBL. Clin Microbiol Newsl. 2018;40(3):19-24.
- Kass EH. Trans Assoc Am Physicians. 1956;69:56-64.
- Kass EH. AMA Arch Intern Med. 1957;100(5):709-714.
- Sathiananthamoorthy S, et al. J Clin Microbiol. 2019;57(3):e01452-18.
- Stamm WE, et al. N Engl J Med. 1982;307(8):463-468.
- Nicolle LE, et al. Clin Infect Dis. 2019;68(10):e83-e110.
- Moreland RB, et al. Clin Microbiol Rev. 2025;38(1):e0012924.
- Yoo JJ, et al. J Clin Med. 2022;11(9):2295.
- Lainhart W, et al. Clin Microbiol Newsl. 2018;40(10):77-82.
- Costales J, et al. Can J Urol. 2019;26(1):9680-9682.
- Diedrich LK, et al. Lab Med. 2017;48(1):e1-e3.
- Hilt EE, et al. J Clin Microbiol. 2014;52(3):871-876.
- Wolfe AJ, et al. J Clin Microbiol. 2012;50(4):1376-1383.
- Roth RS, et al. Clin Microbiol Infect. 2023;29(10):1242-1248.
- Brubaker L, et al. mSystems. 2021;6(4):e01371-20.
- Moreland RB, et al. Front Urol. 2023;3:1212590.
- Yarbrough ML, et al. Clin Chem. 2024;70(6):792-797.
- Bank S, et al. Emerg Infect Dis. 2010;16(1):76-80.
- Reasoner SA, et al. NPJ Biofilms Microbiomes. 2023;9(1):91.
- Vayssier-Taussat M, et al. Front Cell Infect Microbiol. 2014;4:29.
- Coorevits L, et al. Eur J Clin Microbiol Infect Dis. 2017;36(4):635-639.
- Deen NS, et al. Front Cell Infect Microbiol. 2023;13:1210161.
- Barnes HC, et al. J Urol. 2021;206(5):1212-1221.
- Ramanan P, et al. Clin Microbiol Rev. 2017;31(1):e00024-17.
- Huang HS, et al. Clin Microbiol Infect. 2018;24(10):1055-1063.
- Zhang H, et al. Clin Lab Med. 2015;35(2):461-486.
- Blaschke AJ, et al. Diagn Microbiol Infect Dis. 2012;74(4):349-355.
- Dien Bard J, et al. J Clin Microbiol. 2018;56(4):e00018-18.
- Esteban J, et al. J Clin Microbiol. 2023;61(11):e0035723.
- Schmitz JE. Infectious Disease Special Edition. 2024;29(July/August):41-48. bit.ly/4m3KD7F-IDSE
- Bermudez T, et al. J Clin Microbiol. 2025;63(2):e00306-24.
- Boon HA, et al. Fam Pract. 2022;39(4):616-622.
- Athamna A, et al. Eur J Clin Microbiol Infect Dis. 2020;39(10):1855-1863.
- Dhada KS, et al. Characterization of pattern bioscience single-cell microbiology platform for bacteriuria screening. Poster presented at: American Society for Microbiology Microbe; June 13-17, 2024; Atlanta, GA.
- Montgomery S, et al. J Clin Microbiol. 2017;55(6):1802-1811.
- Breteler KB, et al. Scand J Infect Dis. 2011;43(10):771-776.
- Brönnestam R. APMIS. 1999;107(4):437-444.
- Baltekin ö, et al. Proc Natl Acad Sci U S A. 2017;114(34):9170-9175.
- Clinical Laboratory Improvement Amendments. CDC. September 11, 2024. Accessed July 23, 2025. cdc.gov/clia/php/about/index.html
- Medical Devices; Laboratory Developed Tests. Fed Regist. 2024;89(88):37286-37445. 21 CFR Part 809. bit.ly/46GT4AR-IDSE
- Association for Molecular Pathology v US Food and Drug Administration. Case No. 4:24-CV-824-SDJ (ED Tex 2025). bit.ly/4lhycE3-IDSE
- Wojno KJ, et al. Urology. 2020;136:119-126.
- Romero EJM, et al. Open Forum Infect Dis. 2023;10(suppl 2):ofad500.2445.
- He S, et al. BMC Infect Dis. 2024;24:1000.
- Jeff C, et al. Diagn Microbiol Infect Dis. 2025;113(3):116995.
- Haley E, et al. Diagnostics (Basel). 2023;13(19):3060.
Copyright © 2025 McMahon Publishing, 545 West 45th Street, New York, NY 10036. Printed in the USA. All rights reserved, including the right of reproduction, in whole or in part, in any form.

Download to read this article in PDF document:![]() Advances, Opportunities, and Challenges In the Diagnosis of Urinary Tract Infections
Advances, Opportunities, and Challenges In the Diagnosis of Urinary Tract Infections